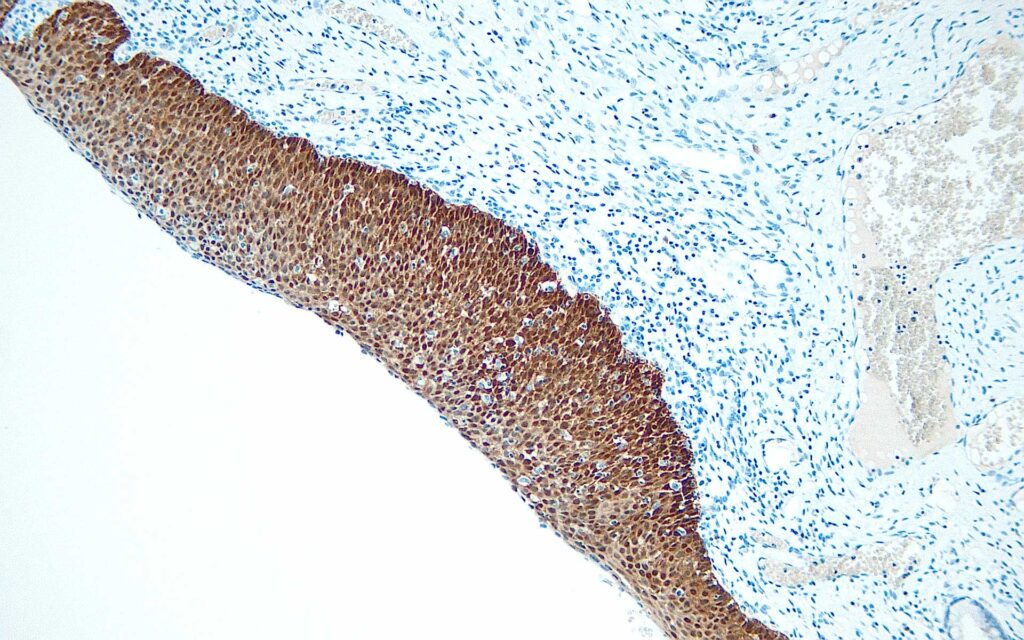

The very first NordiQC assessment of DB Biotech P16 (clone R15-A) and they passed it with distinction!
NordiQC participants conducted an evaluation of the technical performance and level of analytical sensitivity and specificity of IHC assays for p16, to identify HPV-associated cervical lesions in histological cervical samples. Relevant clinical tissues, both normal and neoplastic, were selected to show a broad spectrum of p16 antigen expression.
In this assessment, the NordiQC participants also evaluated p16 antibodies from DB Biotech, of which the clone R15-A (catno: DB 253) produced optimal results.
DB Biotech's Anti-p16 (mouse) (catno: DB 253) can be used for manual and automated IHC applications, the anti-p16 antibody and trial sizes are readily available. The product is IVD and underway for IVDR with already protocols in the IFU from the supplier for different automated platforms.

Are you interested in p16 antibodies?
Do not hesitate to contact us for more information. ForLab supplies all DB Biotech products in the Benelux.





